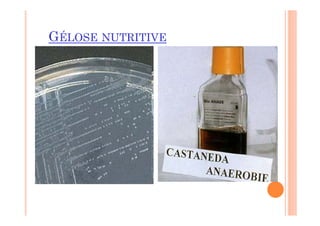
GÉLOSE NUTRITIVE
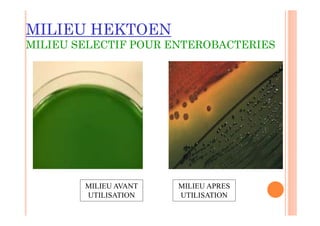
MILIEU HEKTOEN
MILIEU SELECTIF POUR ENTEROBACTERIES
MILIEU AVANT
UTILISATION
MILIEU APRES
UTILISATION

La physiologie bactérienne étudie la nutrition, la croissance et le métabolisme des bactéries en fonction de l'environnement. Les bactéries présentent divers types nutritionnels basés sur leurs besoins élémentaires, énergétiques et spécifiques, influencés par des facteurs comme la température, le pH et la pression osmotique. La croissance bactérienne est caractérisée par une augmentation numérique des cellules, mesurée par différentes techniques, et se divise en plusieurs phases, allant de la latence à la phase de déclin.

![ Le temps de latence est long dans un ½ minimal
synthétique inoculé avec des bactéries provenant d’un
milieu riche contenant de nombreux composés organique
(il correspond au temps nécessaire à la bactérie pour la
synthèse d’enzymes supplémentaires nécessaires à la
biosynthèse)
Phase B: Phase de croissance exponentielle : Le taux de
croissance est constant, il atteint la valeur maximale.
Il est influencé par la T°, le PH, la nature et la [ ] des
aliments.
Phase C: Phase de ralentissement (épuisement du 1/2
de culture et accumulation des déchets)
Phase D: Phase stationnaire: masse bactérienne
maximale (les bactéries vivent sur leurs réserves) sa
durée est variable souvent courte en ½ synthétique.
Phase E: Phase de déclin: La masse bactérienne
décroît du fait de la lyse des bactéries.](https://image.slidesharecdn.com/392279801-cours-1-250105205547-a18a6bd4/85/392279801-coddddddddddddddddddddddurs-1-pdf-37-320.jpg)


